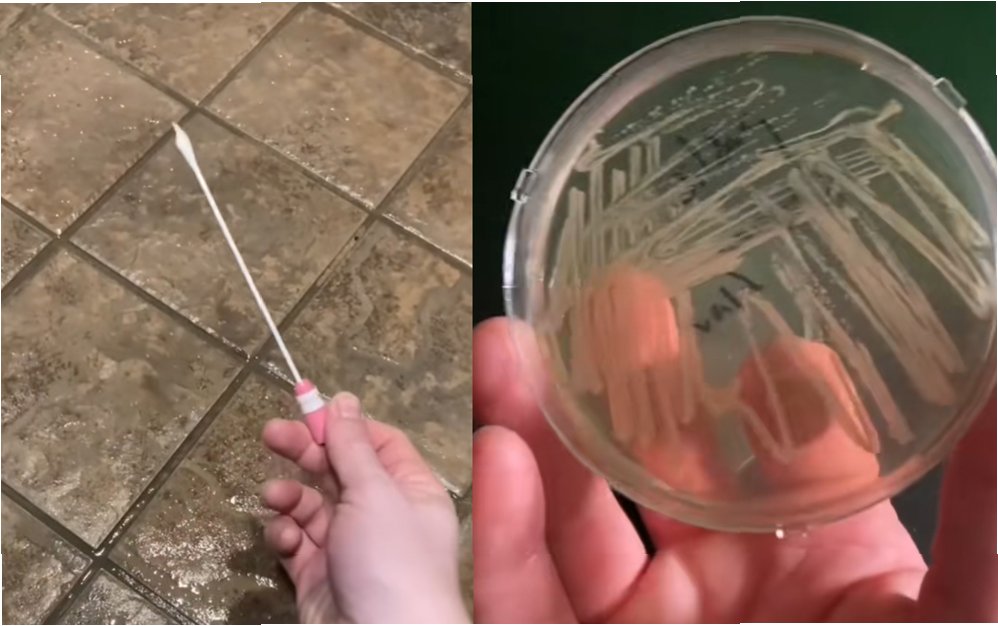

헬스장 샤워실, 생각보다 위험하다?
헬스장 공용 샤워실을 맨발로 이용하는 습관이 자칫 심각한 세균 감염을 불러올 수 있다는 실험 결과가 나와 충격을 주고 있습니다. 영국 데일리메일은 15일(현지시각) 50만 명의 팔로워를 보유한 미생물학자 닉 아이커가 사회관계망서비스(SNS) 틱톡 계정에 올린 실험 영상을 보도했습니다. 체육관 공용 샤워실 바닥의 세균 증식 위험성을 알리기 위해 진행한 이 실험 영상은 약 2만 회의 조회수를 기록하며 주목받았습니다.

미생물학자 닉 아이커의 틱톡 실험
아이커는 영상에서 면봉으로 샤워실 바닥을 문지른 뒤 채취한 검체를 특수 인큐베이터에 배양했습니다. 일정 시간이 지나자 용기 안에서는 두꺼운 박테리아층이 형성되었습니다. 그는 이를 근거로 “이것이 바로 공용 샤워실에서 슬리퍼를 꼭 신어야 하는 이유”라고 강조했습니다.

세균 번식의 온상, 습한 공간
그간 헬스장 내 세균 감염 위험은 전문가를 사이에서 꾸준히 지적되어 왔습니다. 프림로즈 프리스톤 레스터대학교 임상미생물학과 교수는 사우나, 샤워실, 수영장 등 따뜻하고 습한 공간이 세균이 자라기 가장 좋은 환경이라고 밝혔습니다. 그는 "땀은 비타민, 미네랄, 젖산, 아미노산, 지질 등 다양한 성분을 포함하고 있어 세균이 자라기 좋은 영양 공급원이 된다"고 설명했습니다.

헬스장에서 조심해야 할 세균: 포도상구균
헬스장에서 자주 발견되는 병원성 세균으로는 포도상구균이 대표적입니다. 특히 항생제에 잘 듣지 않는 ‘’메티실린 내성 황색포도알균(MRSA)'은 감염 시 통증, 발열, 부종과 같은 심각한 증상을 일으킬 수 있습니다. 영국 국민보건서비스(NHS)는 MRSA가 피부에 있다가 체내로 침투하면 중증 감염으로 이어질 수 있다고 경고했습니다.
감염 위험 줄이는 방법: 슬리퍼 착용과 발 건조
전문가들은 공용 샤워실·수영장·탈의실과 같은 다중이용시설을 이용할 때는 반드시 슬리퍼를 신고, 샤워 후에는 발을 완전히 말리는 등 기본 위생 수칙을 지켜야 감염 위험을 줄일 수 있다고 당부했습니다.

핵심 정리: 헬스장 샤워실, 안전하게 이용하려면?
헬스장 샤워실은 세균 감염의 위험이 도사리고 있습니다. 닉 아이커의 실험 결과와 전문가들의 조언을 통해, 슬리퍼 착용과 발 건조의 중요성을 강조합니다. 안전한 헬스장 이용을 위해 위생 수칙을 꼭 지켜주세요!

자주 묻는 질문: 헬스장 샤워실 안전하게 이용하기
Q.헬스장 샤워실에서 왜 슬리퍼를 신어야 하나요?
A.공용 샤워실 바닥에는 세균이 번식하기 쉬운 환경이 조성되어 있습니다. 슬리퍼는 이러한 세균으로부터 발을 보호하는 역할을 합니다.
Q.MRSA 감염은 얼마나 위험한가요?
A.MRSA는 항생제 내성이 있는 황색포도알균으로, 감염 시 심각한 증상을 유발할 수 있으며, 심한 경우 중증 감염으로 이어질 수 있습니다.
Q.샤워 후 발을 완전히 말려야 하는 이유는 무엇인가요?
A.발을 완전히 말리지 않으면 습한 환경이 조성되어 세균 번식이 더욱 활발해질 수 있습니다. 발을 건조하게 유지하는 것은 세균 감염 예방에 중요한 요소입니다.

'이슈' 카테고리의 다른 글
| 아리아나 그란데 덮친 남성, 징역 9일 선고…'히죽' 웃음 뒤 숨겨진 진실 (0) | 2025.11.18 |
|---|---|
| 공포의 '몰카' 범죄: 사회복지사의 은밀한 촬영, 남성들을 겨냥하다 (0) | 2025.11.18 |
| 순천시, 1인당 20만원 민생회복지원금 지급! 지역 경제 활성화 기대 (0) | 2025.11.18 |
| 30년 국민연금 납부, 은퇴 후 '건보료 폭탄' 현실…노후 불안감 증폭 (0) | 2025.11.18 |
| 개 식용 금지법, 보상 차별에 '뿔난' 보신탕집 주인들... 농장주는 700억, 우리에겐 39억? (1) | 2025.11.18 |